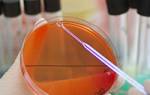

Чрескожная нефролитотомия. Это еще одна возможная операция для удаления крупных камней. Она также может проводиться, если проведение дистанционной ударно-волновой литотрипсии невозможно, например, если человек с камнями в почках страдает ожирением. Чрескожная нефролитотомия проводится с помощью тонкого телескопического инструмента под названием нефроскоп.
Чрескожная нефролитотомия всегда проводится под общим наркозом (вы спите), так что вы не должны садиться за руль автомобиля или управлять какой-либо техникой в течение 48 часов после процедуры. Эффективность подкожной нефролитотомии для удаления камней диаметром 21–30 мм составляет 86%.
Открытое хирургическое вмешательство для удаления почечных камней применяется редко (данный тип операции требуется менее чем в 1% случаев), как правило, если камень очень большой, или при анатомической аномалии. В ходе операции на спине делают разрез для получения доступа к вашему мочеточнику и почке. Затем почечный камень удаляют.
Если у вас образовался уратный камень, вам следует выпивать около трех литров воды в день, чтобы попытаться его растворить. Уратные камни гораздо мягче других типов почечных камней, и они могут уменьшаться от контакта с щелочной жидкостью. Вам может потребоваться прием определенных препаратов для повышения содержания щелочи в моче, прежде чем уратный камень начнет растворяться.
Вам следует сразу же обратиться к врачу в следующих случаях:
- температура 38º C или выше;
- приступ озноба или дрожи;
- боль усиливается, особенно если это резкая, острая боль.
Если у вас появились любые из вышеперечисленных симптомов, немедленно свяжитесь с врачом. Если это не возможно, позвоните по телефону скорой помощи — 03 со стационарного телефона, 112 или 911 — с мобильного.
Лечение почечнокаменной болезни разделяется не неотложную помощь, которая применяется при почечной колике и системную терапию, направленную, в основном, на предотвращение рецидивов.
Для неотложной помощи применяются препараты из группы спазмолитиков, которые можно без проблем приобрести в любой аптеке. Такие лекарства как но-шпа, спазмалгон, баралгин оказывают расслабляющий эффект на стенку мочеточника, чем способствуют прохождению камня в полость мочевого пузыря. Наилучший эффект наблюдается при внутривенном введении препаратов, хотя некоторые врачи настаивают на внутримышечном.
Помимо спазмолитиков во время острого периода применяются немедикаментозные методы коррекции, которые заключаются в назначении горячей ванны и грелки на больное место. Механизм воздействия термических процедур примерно такой же, как и спазмолитиков.
Названные мероприятия можно считать только временными, поскольку почечнокаменная болезнь имеет очень большую склонность к рецидивам. Единственным верным методом избавления от камня в почке считается удаление последнего. На сегодняшний день существует несколько методик подобной операции.
При конкрементах большого объема применяется классическая нефротомия, которая используется еще со времен Николая Пирогова. На сегодняшний день доказано большое количество недостатков подобной операции, но при камнях внушительного размера она остается просто незаменимой.
Что же касается современных тенденций в лечении почечнокаменной болезни, что на данном этапе развития урологии наиболее эффективной и наименее травматической считается ультразвуковая литотрипсия. Суть операции заключается в использовании специального аппарата, который посредством ультразвука дробит камни внутри почки, и последние потом выходят вместе с мочой.
При неоперабельных случаях используется постановка стента в мочеточник, который выполняет роль обходного шунта, по которому происходит отток мочи из почки в мочевой пузырь. Но необходимо помнить, что подобная операция является всего лишь симптоматической и не способная полностью излечить больного. Примерно раз в месяц больной нуждается в замене стента. Стоит отметить, что процедура довольно неприятная и болезненная.
Как показывает практика, больные почечнокаменной болезнью прибегают к народным методам лечения только до возникновения первого приступа почечной колики. Рассматривая ситуацию в общем, можно отметить, что ни одна из схем народного лечения, которые используются при камнях в почках, не дает положительного эффекта в конечном результате. Вариантом исключения можно считать употребление отвара полевого хвоща на ранних стадиях процесса образования камней.
Применяют комплексное индивидуализированное лечение, включающее диету, растворение камней, удаление камней из мочевыводящих путей (с предварительным дроблением камней ультразвуком или без данной процедуры), симптоматическую терапию.
Диета направлена на изменение состава крови с целью устранить причины камнеобразования. При кальциевых камнях потребуется уменьшить молочные и кисломолочные продукты (молоко, сыр, йогурт). При оксалатных камнях необходимо ограничить продукты, содержащие щавелевую кислоту: салат, шпинат, щавель, картофель, апельсины.
При фосфатных камнях требуется подкисление мочи — полностью исключить молочные продукты, ограничить овощи и фрукты, увеличив количество мяса, рыбы и мучных продуктов. При уратных камнях следует ограничить употребление продуктов, способствующих образованию и накоплению мочевой кислоты: печень, почки, мозги, мясные бульоны, мясо рыбу, растительные жиры, пр.
Кроме того рекомендуют свежеприготовленные растворы цитратов (Уралит и пр.), которые растворяют соли мочевой кислоты. Из средств народной медицины применяют свежевыжатый лимонный сок, содержащий цитраты.
Чтобы не делать операцию вначале пытаются растворить камни с помощью препаратов, изменяющие кислотно-щелочное состояние крови и мочи. Для растворения цистиновых камней применяют Уралит, оксалатных камней – Пролит, фосфатных камней – Марилин.
Если камни растворить не удалось, проводят их удаление. Чтобы избежать удаление камней с помощью разреза лоханки или почки, вначале проводят их дробление ультразвуком; при этом в большинстве случаев удается вывести образовавшиеся мелкие фрагменты с током мочи. Дробление может быть проведено дистанционно (дистанционная ударно-волновая литотрипсия – воздействие на камень проводят даже без разреза кожи);
Если камни раздробить не удалось или в мочевыводящих путях остались их фрагменты, проводят операцию по удалению камней или фрагментов. Операцию выполняют через разрез лоханки (пиелолитотомия) или тела почки (нефролитотомия). Хирургическое удаления камней из мочеточника называют уретеролитотрипсией.
Причины образования камней в почках
Почечнокаменная болезнь – одна из тех патологий, ведение и лечение которой проходит под строгим контролем диеты. В данной ситуации назначается 7 стол по Певзнеру, основная суть которого заключается в уменьшении количества потребляемой соли, жирных продуктов и экстрактивных веществ, которые способствуют образованию камней в почках. Также строго контролируется водный режим, для того чтобы сильно не нагружать итак пораженный орган.
При воспалительных сужениях уретры, развитии аденомы предстательной железы и при хронических простатитах нарушается нормальный отток мочи, что ведёт к развитию застойных явлений в почках и выпадению солей в осадок. Из них, в конечном итоге, и образуются камни. Сначала небольшие, песчинки постепенно увеличиваются в размерах, обрастают новыми солевыми отложениями и превращаются в образования, способные, в особенно тяжёлых случаях, перекрыть мочеточник. Это может привести к тяжёлому осложнению — гидронефрозу почки и развитию почечной недостаточности.
Кроме этих особенностей, свойственных мужскому организму, есть ещё ряд факторов, которые способствуют развитию мочекаменной болезни:
- Жесткая питьевая вода. Появление камней в почках очень часто является следствием употребления некачественной питьевой воды. Во многих регионах нашей страны вода очень жёсткая, содержит излишнее количество солей кальция (см. Выбор фильтра для воды).
- Питание. Неправильное питание, когда в пище значительно преобладает мясо, ведёт к образованию уратных солей. Если в рационе слишком много творога и молока, есть опасность развития кальциевых конкрементов.
- Недостаточный питьевой режим. Камнеобразованию может способствовать недостаточное поступление воды в организм. Чаще всего такая ситуация встречается на территориях с жарким климатом, когда организм теряет много жидкости с потом (см. Как поддержать водный баланс в мужском организме).
- Инфекции и лекарственные средства. Мочеполовые инфекции и ряд лекарственных препаратов могут также быть причинами образования конкрементов.
Все указанные факторы являются предрасполагающими. Окончательная причина формирования камней до конца не выяснена.
Существует множество предположений, однако все учёные склоняются к тому, что заболевание связано с особенностями обмена и имеет наследственную предрасположенность. Так что, если в семье кто-то страдает мочекаменной болезнью, детям и внукам надо быть очень внимательными: придерживаться диеты, избегать употребления жёсткой воды, избегать мочеполовых инфекций и т. д.
- длительные воспалительные процессы мочеполовой системы;
- расстройства в работе ЖКТ, в т.ч. нарушения кислотно-щелочного бананса;
- дефицит в организме витаминов группы Д и Е;
- малоподвижный образ жизни;
- малое потребление жидкостей;
- чрезмерное употребление газированных сладких напитков;
- завышенное потребление соли
- жаркий климат;
- нарушение обменных процессов;
- при гормональном дисбалансе;
- наследственные факторы и пр.
Для возможности диагностировать заболевание на ранних стадиях развития специалисты рекомендуют каждому взрослом человеку ежегодно проводить полноценное обследование у уролога.
Чтобы точно знать, как определить как камни в почках начинают свое образование, нужно быть осведомленными в проявлении основных симптомов. Также важно обратить внимание на один немаловажный фактор – мочекаменная болезнь весьма коварна, и по настоящему начинает проявляться только в тот момент, когда ее развитие зашло уже далеко.
Основные признаки камней в почках:
- ноющие, иногда жгучие боли в пояснице, внизу живота или в боку;
- кровяные примеси в моче;
- задержка процесса мочеиспускания;
- боли в процессе мочеиспускания;
- частые позывы к мочеиспусканию;
- почечные колики;
- повышенная температура, часто в допустимых нормах – до 37 градусов;
- тошнота или лихорадка и пр.
Большинство описанных симптомов имеют сходство с другими заболеваниями или имеют краткосрочный характер проявления, как например, почечные колики. Поэтому пациенты на них вообще не обращают свое внимание. В результате слишком поздно обращаются за помощью к специалистам, когда остается единственный метод – оперативное вмешательство.
Симптомы проявления мочекаменной болезни у мужчин, практически ничем не отличаются от аналогичных проявлений в женском организме. Единственное отличие в расположении камней, конкретнее – выход образований через мочеиспускательный канал.
Важно отметить еще одну особенность поведения пациентов: частые позывы к мочеиспусканию провоцируют желание удержания мочи, что может привести к глобальным последствиям, например, к отравлению токсинами. Специалисты рекомендуют не провоцировать еще большие нарушения, и при первом же желании посетить туалетную комнату незамедлительно отреагировать на позывы организма.
Осложнения камней в почках
Осложнения в результате образования камней в почках встречаются редко, так как обычно камни находят и лечат до возникновения дополнительных осложнений. Однако, если камни вызывают непроходимость мочеточников и нарушают отток мочи, возникает риск инфекции, которая может повредить почку.
Наиболее распространенным осложнением является повторное образование камней в почках. Если у человека был обнаружен камень в почке, вероятность того, что камень возникнет повторно, составляет 60–80%.
Различные методы лечения более крупных камней могут привести к некоторым осложнениям. Хирург должен объяснить их вам до того, как проводить процедуру по их удалению. В зависимости от выбранного метода лечения возможно развитие следующих осложнений:
- сепсис — инфекция распространяется через кровь и вызывает симптомы по всему организму;
- «каменная дорожка» — медицинское название непроходимости, вызванной фрагментами камней в мочеточнике (трубке, соединяющей каждую почку с мочевым пузырем);
- повреждение мочеточника;
- инфекция моче-выводящих путей;
- кровотечение во время операции;
- боль.
По некоторым оценкам, 5–9% людей могут испытывать боль после прохождения уретроскопии.
Наиболее грозным осложнением почечнокаменной болезни необходимо считать двустороннюю почечную колику. В той ситуации, когда она сопровождается застоем мочи в обеих почках, происходит выброс патологических продуктов обмена в кровь. Это сопровождается ухудшением общего состояния больного и возникновением симптомов со стороны нервной системы. Критической точкой в развитии почечной энцефалопатии считается почечная кома, которая, как правило, заканчивается летальным исходом.
Не менее опасным осложнением можно считать инфицирование почки, которому способствует наличие конкрементов. В подобной ситуации развивается пиелонефрит, который может осложниться абсцессом почки или даже гнойным воспалением околопочечной клетчатки.
- мочевая система может быть инфицирована, здесь может развиться пиелонефрит в острой или хронической форме, забрюшинное пространство может подвергнуться нагноению, так что лечение должно быть своевременным;
- гидронефроз, который представляет собой процесс перерастяжения почечной лоханки, что приводит к атрофированию почечных тканей. И вот тогда можно говорить уже о фактической гибели почки, которая начинает представлять собой мочевой мешок, здесь нередко лечение не принесет положительных результатов;
- почечная недостаточность в хронической форме. Давление мочи становится повышенным в результате воздействия камней, все это сочетается с хронической инфекцией, фильтрующий аппарат почек начинает разрушаться, что приводит к склерозу тканей. Все это приводит к печальному итоге — почки больше не могут полноценно выполнять свои функции, и тогда мочеобразование может вообще полностью прекратиться.
К какому врачу обратиться при камнях в почках
С помощью сервиса НаПоправку вы можете найти хорошего нефролога — специалиста по болезням почек. Если вам необходима операция, выберите надежную нефрологическую клинику, ознакомившись с отзывами о ней.
-
Камни в почках или что-то еще?
Здравствуйте. Дня 3 назад я пошел в туалет и ощутил резь в мочеиспускательном канале. Сейчас уже не так больно, как было. Но именно в том месте, где чувствовал резь могу нащупать пальцем бугорок. В связи с работой врачу смогу показаться месяца через 2. Скажите пожалуйста, что это может быть и как можно себе помочь? Половые контакты были только с женой на протяжении последних 6.5 лет. Спасибо.